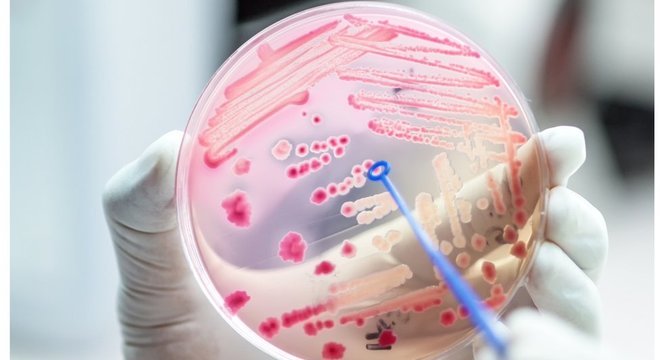

Cientista observa micróbios em laboratório; estudo identifica que relação entre células humanas e micróbios não é equilibrada
Getty Images /BBC NEWS BRASILCerca de metade de nós não somos nós. Melhor dizendo: somos 50% humanos e 50% micróbios - o microbioma, esse conjunto de trilhões e trilhões de bactérias, vírus, fungos e outros organismos minúsculos que habitam nossos órgãos e tecidos.
Mas se engana quem pensa que a relação entre nós e eles seja de igual para igual. O que cientistas americanos acabam de descobrir é que, ao longo da evolução, os animais domamos os micróbios - e este controle garantiu que eles fossem úteis ao nosso organismo, sem que nos dominassem.
"Acreditamos que esse processo evoluiu de forma a beneficiar os humanos", comentou à BBC News Brasil o engenheiro biomédico Lawrence David, professor de genética molecular e microbiologia da Universidade Duke, nos Estados Unidos.
A lógica desse fenômeno, conforme os cientistas explicam em artigo publicado nesta segunda, 29, no periódico Nature Microbiology, é uma relação de causa e consequência semelhante à que acontece em um lago, na natureza: se há muitos nutrientes sobrando, o local se torna pantanoso, repleto de algas e beirando a insalubridade.
Isso é chamado de eutrofização. Acontece devido ao aumento das concentrações de nitrogênio ou fósforo na água, causando um desequilíbrio que acaba prejudicando o ecossistema.
Conforme concluiu a equipe de David, portanto, o segredo para termos domado nosso microbioma - e, ao longo do tempo, feito desses bichinhos nossos úteis hóspedes - está no fato de que nosso organismo sempre os deixa com fome.
Dependência e dominação
Os animais - inclusive os seres humanos - dependem das comunidades de micróbios que vivem em seus corpos. É graças a esses serezinhos que conseguimos digerir alimentos, sintetizar vitaminas, fortalecer sistemas imunológicos e realizar uma vasta gama de fenômenos bioquímicos.
Ao mesmo tempo, esses microorganismos não conseguiriam viver sem os animais como seus hospedeiros.
Por décadas, pesquisadores acreditavam que essa relação de interdependência fosse uma simbiose equilibrada, um ganha-ganha em que não houvesse um dominante.
Pois é exatamente isso que a atual pesquisa contraria. Essa relação entre hospedeiros e hóspedes não é nenhum conto de fadas. Os cientistas descobriram que, em nome do benefício próprio, os animais privam seus micróbios de nutrientes. Deixando-os com fome, eles são escravizados - e acabam fazendo o serviço que precisamos.
"Há uma hierarquia natural entre as bactérias e nós", afirma David. "E nós, como anfitriões, damos as cartas neste jogo."
Abundância e escassez
Acreditava-se que, para o microbioma, o intestino fosse um paraíso de nutrientes. Ou, nas palavras de David, um local "onde abundam alimentos e recursos, uma verdadeira Fábrica de Chocolate de Willy Wonka". Não é à toa que, de acordo com estudos, existem mais bactérias residindo por grama no intestino do que em qualquer outro ecossistema do mundo. No total, a soma desses microorganismos do intestino chega a 3 quilos em um ser humano - é muito, o equivalente ao fígado ou ao cérebro.
A crença, portanto, era que essa abundância fosse resultado da hospitalidade do intestino. O local seria tão agradável a esses bichinhos, que as condições teriam favorecido essa proliferação - benéfica para os animais, pois o microbioma ajuda na digestão.
Entretanto, agora se descobriu que não é bem assim. Os pesquisadores analisaram essa estrutura e concluíram que ela reproduz qualquer outro ecossistema do planeta, ou seja, é um ambiente em que os seres vivos competem entre si pelos recursos.

Os cientistas descobriram que os micróbios nos intestinos dos mamíferos replicam os mesmos ecossistemas do planeta
Getty Images /BBC NEWS BRASILPara tanto, foram medidas as proporções de nitrogênio das fezes de diversos animais. No total, foram analisados mais de 30 tipos de mamíferos - zebras, girafas, elefantes, ovelhas, bois, humanos etc.
As amostras de fezes foram trituradas e, em seguida, no laboratório, tiveram os átomos de nitrogênio e carbono contados.
E aí veio a descoberta: descobriu-se que os micróbios no intestino humano têm acesso a uma média de apenas um átomo de nitrogênio para cada dez átomos de carbono - enquanto os micróbios de vida livre desfrutam de uma dieta composta de um nitrogênio a cada quatro carbonos.
Trocando em miúdos: os bichinhos que habitam seu organismo estão com fome. E isso é bom.
"O que descobrimos é que os animais desenvolveram uma maneira de manter as bactérias 'na coleira', deixando-as famintas por nitrogênio", explica David. "Como os micróbios do intestino dependem dos nutrientes que fornecemos, podemos controlar quais bactérias crescem e quanto elas crescem."
Partindo dessa premissa como verdadeira, uma outra analogia foi feita pelos cientistas: a de como a vida ocidental, com os hábitos alimentares não muito saudáveis e o uso e o abuso de antibióticos, pode estar atrapalhando essa relação. "O estudo também sugere por que a dieta ocidental pode ser ruim para nós. Quando as pessoas ingerem muita proteína, isso prejudica a capacidade de o hospedeiro absorver esse nitrogênio do intestino delgado. Assim, mais nitrogênio acaba chegando ao intestino grosso. Esse desequilíbrio mina nossa capacidade de controlar as comunidades microbianas", aponta o cientista.
"Uma maneira de explicar o estudo é comparar nossos intestinos aos lagos", exemplifica David. "Normalmente, os lagos não contêm muitos nutrientes em excesso. Mas, quando fertilizantes acabam despejados neles, esses ecossistemas mudam e você vê florescerem muitos organismos indesejados, como as algas. Essa pesquisa sugere que um fenômeno semelhante ocorre no intestino, onde quando muito nitrogênio é ingerido, em forma de proteína, podem ocorrer desenvolvimentos anormais de bactérias."
Saúde
Esses hábitos podem deixar a relação de poder mais favorável aos micróbios, portanto. Em última análise, enfraquece nosso organismo, deixando-nos mais vulneráveis a doenças.
Por essa teoria, se os humanos estão "perdendo o controle" sobre os micróbios, parece natural imaginar que o uso de antibióticos, ao eliminar populações inteiras de microorganismos, seria uma solução para mostrar, afinal, quem é que manda no pedaço.
Mas não é bem assim. Um estudo anterior realizado pela mesma equipe mostrou que tal comportamento seria imprudente, um verdadeiro tiro no pé. Na ocasião, eles deram medicamentos a dez camundongos e passaram a monitorar suas fezes diariamente. Notaram que quando os micróbios se esgotaram, o intestino dos ratos começou a acumular as fontes de alimento dos microorganismos. Pouco tempo depois, o microbioma passou a florescer novamente, mas de modo mais intenso e desequilibrado.
Os cientistas não sabem qual seria o "número ideal" de bactérias no intestino, mas estão convencidos de que é preciso um equilíbrio.
No caso de seres humanos, eles acreditam que após o uso de antibióticos, o microbioma fica alterado por meses ou até anos. E essa alteração acaba deixando o organismo mais fértil para a invasão de bactérias nocivas e causadoras de doenças. "Normalmente, os patógenos têm dificuldade em colonizar o intestino. Afinal, há trilhões de outras bactérias ali, que eles precisam vencer para sobreviver. Mas se, de repente, tirarmos a competição microbiana por recursos, perdemos o controle, e as bactérias ruins que causam doenças desagradáveis encontram um caminho aberto", explica David.


.jpg)
